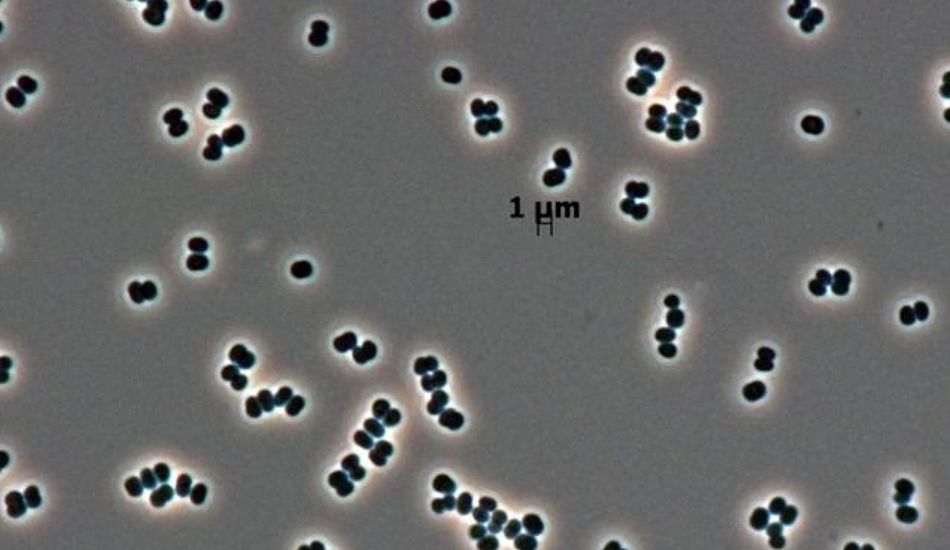
Sobrevivência Microbe

Este Microbe Espacial Simula a Morte em Salas Limpas da NASA: Uma História de Sobrevivência
Sabe, são sempre as pequenas coisas que nos surpreendem. Neste caso, é um micróbio chamado Tersicoccus phoenicis. Em 2007, a NASA encontrou este pequeno ser vivo relaxando em salas superlimpas onde constroem naves espaciais. Estas salas são praticamente estéreis, então encontrar vida lá foi uma grande dor de cabeça.
Durante anos, os cientistas ficaram intrigados sobre como ele chegou lá. Mas um estudo recente na Environmental Microbiology sugere que ele basicamente se faz de morto. Quero dizer, quão legal é isso? Como Madhan Tirumalai, o autor principal do estudo, disse, "Não está morto. Estava se fazendo de morto. Está apenas dormente."
Por que Isso Importa
O objetivo principal destas salas limpas é prevenir a contaminação, especialmente quando estamos enviando rovers para lugares como Marte. A última coisa que você quer é encontrar micróbios terrestres em vez de alienígenas. Então, eles fazem de tudo com a limpeza – aquecimento, secagem, produtos químicos, luz UV, o que você imaginar. Em seguida, verificam novamente para garantir que nada esteja vivo.
O que é realmente impressionante é que o T. phoenicis não só sobreviveu, mas também enganou as verificações de esterilização. Mesmo que a NASA tenha garantido a todos em 2013 que não era prejudicial, os pesquisadores por trás deste novo estudo queriam investigar mais a fundo.
Em seu experimento, eles colocaram T. phoenicis em placas estéreis, privaram-no de nutrientes e o secaram. Eis que, em 48 horas, a bactéria entrou em um estado dormente, parecendo sem vida. E permaneceu assim por uma semana inteira, mesmo quando tentaram alimentá-lo novamente.
O ponto crucial? Expondo-o a uma certa proteína, trouxe-o de volta à vida. Isso é como algo saído de um filme de ficção científica! Nils Averesch, um microbiologista da Universidade da Flórida, apontou que essa capacidade de desligar o metabolismo torna muito mais provável que essas bactérias sobrevivam em superfícies de naves espaciais.
Agora, aqui é onde fica um pouco preocupante. T. phoenicis foi encontrado pela primeira vez durante os preparativos para o pousador Phoenix Mars. Então, poderia ter pegado uma carona para Marte sem ser notado?
Especialistas acham improvável que sobreviva na superfície marciana, mas ainda é um pensamento. Também é possível que o T. phoenicis tenha evoluído especificamente para sobreviver em salas limpas de naves espaciais, já que não foi encontrado em nenhum outro lugar. No entanto, esta descoberta também pode nos ajudar a melhorar os métodos de limpeza nestas salas. Agora que sabemos como acordar estas bactérias, podemos atacá-las de forma mais eficaz.
No final, este truque metabólico apenas mostra o quão incrivelmente resistentes até mesmo as menores formas de vida podem ser. Faz você se perguntar quais outros segredos eles estão escondendo!
2 Imagens de Sobrevivência Microbe:




Fonte: Gizmodo